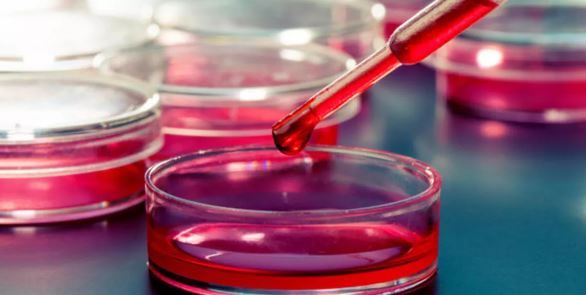
Foto - Kan testiyle kanseri tespit ettiler

Kan testiyle kanseri tespit ettiler
Oxford Üniversitesi tarafından 5 bin kişiyle yapılan testlerde, kandan kanser teşhisi mümkün oldu.
Oxford Üniversitesi tarafından 5 bin kişiyle yapılan testlerde, kandan kanser teşhisi mümkün oldu.
İngiltere'de kan testiyle kanser tespitine imza atıldı.
Ulusal Sağlık Hizmetleri'nin (NHS) gerçekleştirdiği kan testi sayesinde her üç kanserden ikisi saptandı.
BBC’nin haberine göre, kan testi İngiltere ve Galler’de aile hekimlerine şüpheli belirtilerle başvuran 5 bin kişiye yapıldı.
Her üç kanserden ikisinin tespit edildiği testin 50’den fazla kanser tipinin tespiti konusunda umut vadettiği belirtildi.
“Galleri” isimli testte pozitif vakaların yüzde 85’inde kanserin asıl noktası da saptandı.
Oxford Üniversitesi'nden araştırmacılar, testin “devam eden bir çalışma olduğunu” ancak erken teşhis sayısının artabileceğini bildirdi.
Araştırmaya katılanların 350’den fazlasına tarama ve biyopsiler gibi geleneksel yöntemler kullanılarak kanser teşhisi konuldu.
Endoskopi ve tarama arasında karar verilebilecek Kan testi pozitif çıkan hastaların yüzde 75’inin, negatif çıkanların ise yüzde 2,5’inin kanser olduğu tespit edildi.
Araştırmacılardan Prof. Mark Middleton, “Testten elde edilen tahmin ile hastalar için endoskopi mi yoksa tarama mı isteyeceğimize karar verebileceğiz.” açıklamasında bulundu.
Testin bulguları, Chicago’da düzenlenecek Amerikan Klinik Onkoloji Derneğinin konferansında sunulacak ve The Lancet Oncology dergisinde yayınlanacak. Kaynak: AA
WhatsApp İhbar Hattı
+90 (553) 313 94 23